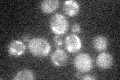
YNL279W

View description
Pheromone-regulated multispanning membrane protein involved in membrane fusion during mating; predicted to have 5 transmembrane segments and a coiled coil domain; localizes to the shmoo tip; regulated by Ste12p
Localization:
Intensity:
Fold change:
Significance:
-
C’ GFP library in SD

below threshold17.43 -
N' NOP1pr-GFP in SD

vacuole,bud neck52.275 -
N' TEF2pr-mCherry in SD

cell periphery,vacuole84.0109 -
N' NATIVEpr-GFP in SD

below threshold17.8156 -
N' TEF2pr-VC and Cyto-VN in SD

#N/A0 -
C’ GFP library in SD+DTT

cytosolN/AN/ANo -
C’ GFP library in SD+H2O2
cytosol15.540.89No -
C’ GFP library in Starvation Media

cytosol16.770.96No -
C’ GFP library on the background of Pup2-DaMP

below threshold -
C’ GFP library on the background of CCT mutant

below threshold14.82230.849829No
